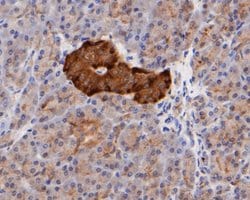
Invitrogen ICAD Recombinant Rabbit Monoclonal Antibody (JE49-23) 100 &mu;L;

missing translation for 'onlineSavingsMsg'
Learn More
Learn More
Invitrogen™ ICAD Recombinant Rabbit Monoclonal Antibody (JE49-23)


Rabbit Recombinant Monoclonal Antibody
Brand: Invitrogen™ MA542485
This item is not returnable.
View return policy
Description
Positive Control: Jurkat cell lysate, human stomach tissue lysate, human thyroid tissue, human breast tissue, human small intestine tissue, human pancreas intestine tissue, HCT116. Subcellular Location: Cytoplasm.
ICAD is the inhibitor of caspase-3-activated DNase which is a substrate that controls nuclear apoptosis. ICAD has two isoforms: a functional isoform of 45kDa, ICAD-L/DNA fragmentation factor (DFF) 45; and a 35kDa isoform, ICAD-S/DFF35. Although both ICAD-L and ICAD-S can bind and inhibit CAD, only ICAD-L was reported to be functional. ICAD is cleaved to be inactivated and allow caspase-activated DNase (CAD) to execute nuclear internucleosomal apoptotic DNA fragmentation. In non-apoptotic cells, CAD is complexed with its inhibitor, ICAD. The activation of the CAD/ICAD complex occurs through the caspase 3-mediated cleavage of ICAD at residues 117 and 224, which results in three ICAD fragments that are then released from CAD. In addition to its DNase inhibitory activity, ICAD acts as a CAD specific folding chaperone. There are recent reports that ICAD is a potential target for restoring a normal apoptotic signal transduction pathway in colon and brain cancer cells. Two alternatively spliced transcript variants encoding distinct isoforms have been found for the ICAD gene.
Specifications
| ICAD | |
| Recombinant Monoclonal | |
| 1 mg/mL | |
| TBS with 40% glycerol and 0.05% sodium azide; pH 7.4 | |
| O00273 | |
| DFFA | |
| Recombinant protein within human ICAD aa 37-137. | |
| 100 μL | |
| Primary | |
| Human | |
| Antibody | |
| IgG |
| Flow Cytometry, Immunohistochemistry (Paraffin), Western Blot | |
| JE49-23 | |
| Unconjugated | |
| DFFA | |
| A330085O09Rik; DFF; DFF1; DFF35; Dff45; DFF-45; Dffa; DNA fragmentation factor 45 kDa subunit; DNA fragmentation factor subunit alpha; DNA fragmentation factor, 45kDa, alpha polypeptide; DNA fragmentation factor, alpha subunit; H13; ICAD; ICAD-L; ICAD-S; Inhibitor of CAD; RP23-121D17.3 | |
| Rabbit | |
| Protein A | |
| RUO | |
| 1676 | |
| Store at 4°C short term. For long term storage, store at -20°C, avoiding freeze/thaw cycles. | |
| Liquid |
Product Content Correction
Your input is important to us. Please complete this form to provide feedback related to the content on this product.
Product Title
Spot an opportunity for improvement?Share a Content Correction